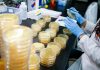
Coronavirus en IL: confirman 4 casos y 286 personas bajo revisión – Telemundo Chicago

Los índices Dow Jones, Nasdaq y S&P 500 han crecido más del 2 % este jueves.
Los principales índices de la Bolsa de Nueva York han seguido subiendo este 26 de marzo.
De esta manera, el Dow Jones recuperó 923,89 puntos (el 4,36 %) y alcanzó los 22.124,44 puntos. Por su parte, el Nasdaq creció 227,87 puntos (el 3,09 %), hasta los 7.612,17, mientras que el S&P 500 aumentó en 92,48 puntos (el 3,74 %), situándose en 2.568,04 puntos.
![]()
El crecimiento se produce a pesar del anuncio momentos antes de datos récord sobre las solicitudes de desempleo en EE.UU. Su número superó los 3 millones la semana pasada tras las estrictas medidas decretadas para contener la pandemia de coronavirus, que incluyen el cierre de negocios.
El Departamento de Trabajo de EE.UU. informó el viernes sobre un número récord de solicitudes de desempleo situado en 3,28 millones. El número rompe la marca de todos los tiempos de 695.000, registrado en octubre de 1982.
La economía de EE.UU. «podría estar en recesión»
Mientras tanto, el presidente de la Reserva Federal de EE.UU. (Fed), Jerome Powell, declaró este jueves que la economía de su país «podría estar en recesión«.
«Pero apuntaría a la diferencia entre esta y una recesión normal. No hay nada fundamentalmente malo con nuestra economía. Muy por el contrario. Empezamos desde una posición muy fuerte», destacó.
Powell declaró que EE.UU. vive «una situación única», cuando las autoridades piden a los ciudadanos cerrar sus negocios y quedarse en casa. «En un momento dado, tendremos al virus bajo control y la confianza regresará», precisó.


![WhatsApp sería destronado ante clásico rival que añadió increíbles funciones [FOTOS] – LaRepública.pe](https://www.condesi.pe/blog/wp-content/uploads/2019/10/nmprofetimg-28-218x150.png)